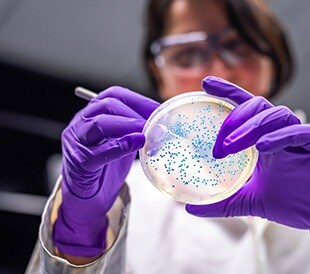
Scientist examining colonies on petri dish

Within the fast-paced and highly competitive field of contra...
Read More Why Every Emerging CRO Should Consider Implementing a LIMS
Making the digital transformation of the lab meaningful, relatable and accessible for scientists and researchers across all industries and fields of study
Making the digital transformation of the lab meaningful, relatable and accessible for scientists and researchers across all industries and fields of study

Within the fast-paced and highly competitive field of contra... by Sarah Yesford / 05.29.2024
Read More Why Every Emerging CRO Should Consider Implementing a LIMS
In the rapidly evolving landscape of bioanalysis, the challe... by Sarah Yesford / 11.29.2023
Read More Navigating Data Integrity in Bioanalytical Labs
This week, Thermo Fisher Scientific LIMS and laboratory soft... by michaelryan / 11.12.2021
Read More Recapping Launch 2021 Virtual
New features and functionality in Watson LIMS software 7.6.1... by Laura Marozsan / 05.26.2021
Read More Watson LIMS Software Advances Immunogenicity and ADA Analysis Capabilities
A Collaborative Workshop to Discuss Bioanalysis The Workshop... by ConnectedLab Staff / 04.26.2018
Read More WRIB 2018 – A Workshop on Recent Issues in Bioanalysis